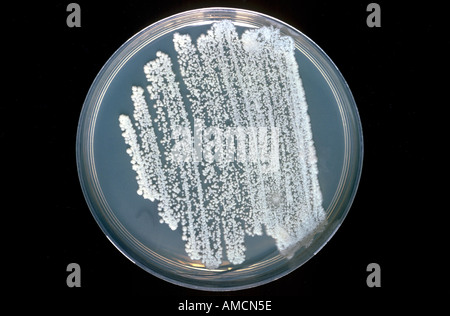
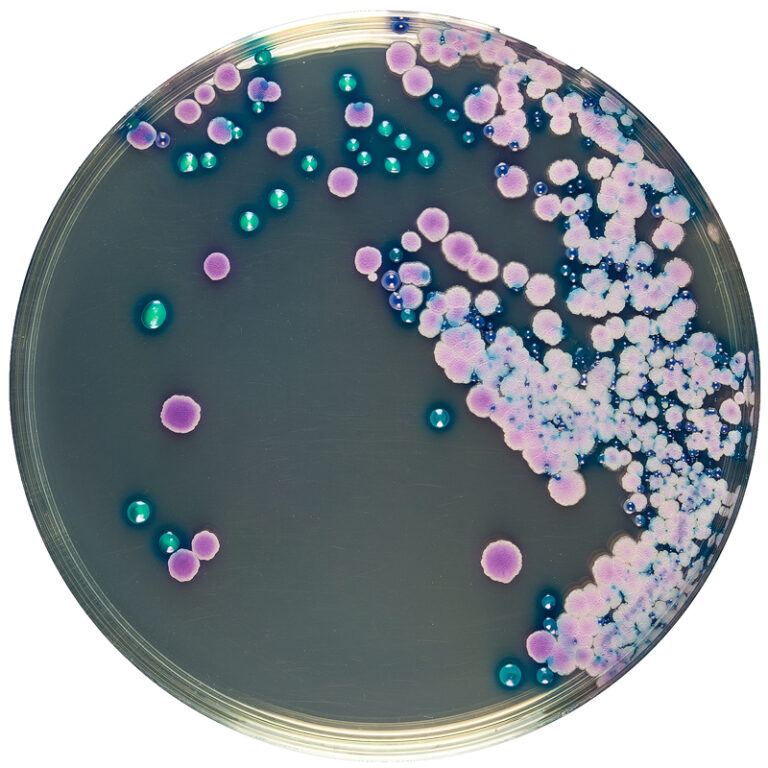
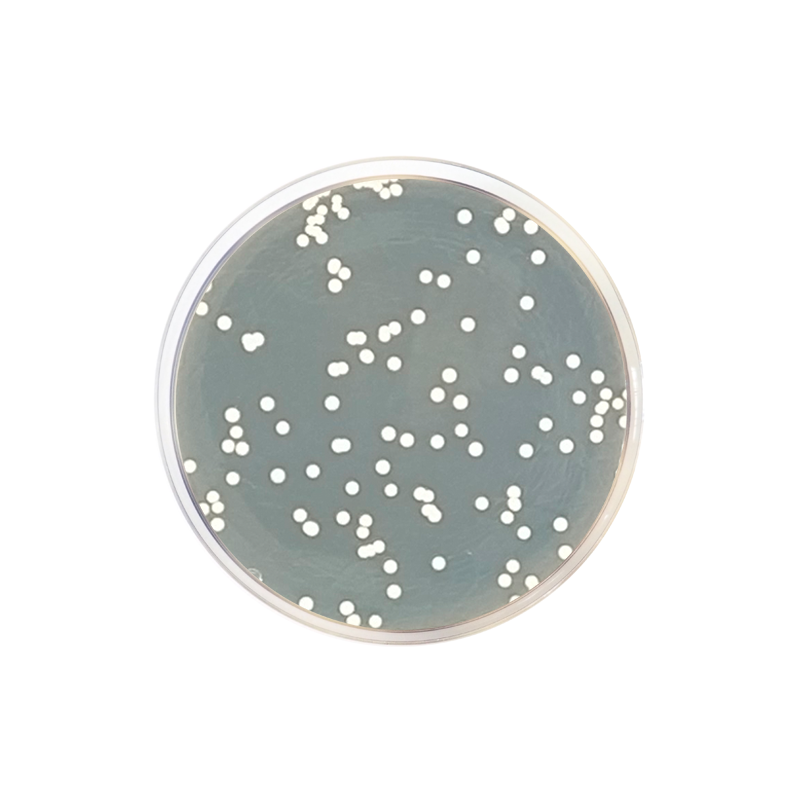

Кандида агар
Тц европа отделы
Как найти выездные
Пожелание выпускникам 11 класса короткое от родителей
Чашки петри 60 мм
Можно ли детям ездить без бустера
Удобрение картофеля аммиачной селитрой
Второе пожизненное лишение свободы
Двухэтапная подготовка к колоноскопии
Feso4 bano32
44 46 размер одежды женской
Сброс китайской магнитолы андроид
Агентство недвижимости надежность
Народный средство от костей
Кандида агар 113 фотографий